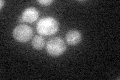
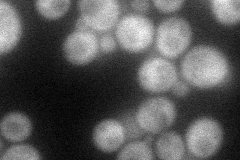
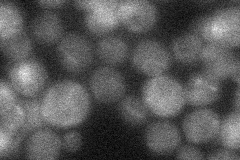
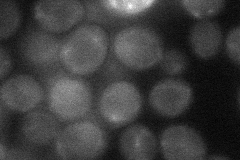
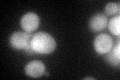

View description
Membrane protein that binds the ubiquitin ligase Rsp5p via its 2 PY motifs; overexpression confers resistance to the GST substrate o-dinitrobenzene,zinc, and calcium; proposed to regulate the endocytosis of plasma membrane proteins
Localization:
Intensity:
Fold change:
Significance:
-
C’ GFP library in SD
cytosol30.61 -
N' NOP1pr-GFP in SD

cytosol50.5149 -
N' TEF2pr-mCherry in SD
cytosol47.9602 -
N' NATIVEpr-GFP in SD
cytosol18.4916 -
N' TEF2pr-VC and Cyto-VN in SD
cytosol30.9058 -
C’ GFP library in SD+DTT
cytosol35.981.17No -
C’ GFP library in SD+H2O2

cytosol36.051.17No -
C’ GFP library in Starvation Media

cytosol32.631.06No -
C’ GFP library on the background of Pup2-DaMP

cytosol -
C’ GFP library on the background of CCT mutant

cytosol32.86171.07312No
